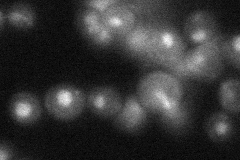
YNL317W

View description
Integral subunit of the pre-mRNA cleavage and polyadenylation factor (CPF) complex; plays an essential role in mRNA 3'-end formation by bridging different processing factors and thereby promoting the assembly of the processing complex
Localization:
Intensity:
Fold change:
Significance:
-
C’ GFP library in SD

nucleus26.24 -
N' NOP1pr-GFP in SD

cytosol,nucleus50.6906 -
N' TEF2pr-mCherry in SD

cytosol,nucleus31.2366 -
N' NATIVEpr-GFP in SD
nucleus35.6065 -
N' TEF2pr-VC and Cyto-VN in SD

below threshold26.4622 -
C’ GFP library in SD+DTT

nucleus27.121.03No -
C’ GFP library in SD+H2O2

nucleus23.780.9No -
C’ GFP library in Starvation Media

nucleus25.130.95No -
C’ GFP library on the background of Pup2-DaMP

N/A -
C’ GFP library on the background of CCT mutant

N/A0N/AYes
